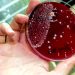
Sebabkan Kematian Usai 48 Jam Terinfeksi, Bakteri Pemakan Daging Gegerkan Jepang

Teras Merdeka – Kesehatan paru-paru menjadi poin yang wajib diperhatikan lantaran berhubungan dengan sistem pernapasan dan sirkulasi darah. Fungsi utama paru-paru yakni menukar oksigen yang dihirup dengan karbon dioksida dari darah.
Penting untuk mengetahui beberapa tanda kerusakan yang terjadi di paru-paru. Karena saat kerusakan terjadi, proses pernapasan jadi terganggu. Dampaknya, suplai oksigen ke seluruh tubuh jadi terhambat atau berkurang.
Gejala-gejala ini penting untuk diwaspadai karena bisa jadi merupakan tanda awal penyakit paru-paru, termasuk penyakit paru obstruktif kronis (PPOK), asma, dan kanker paru-paru.
Selain itu, mengetahui tanda-tanda peringatan dini penyakit paru-paru dapat membantu tindakan atau pengobatan sebelum semakin parah.
Berikut beberapa tanda paru-paru rusak menurut American Lung Association:
Batuk Kronis
Batuk yang terjadi selama delapan minggu atau lebih dianggap sebagai bentuk batuk kronis. Kondisi ini merupakan tanda penyakit paru-paru yang penting untuk diwaspadai.
Sesak Napas
Tidak normal untuk mengalami sesak napas yang tidak kunjung hilang setelah berolahraga atau aktivitas fisik. Napas yang sesak merupakan tanda peringatan gejala paru-paru rusak.
Bengek
Napas yang bising atau bengek adalah tanda bahwa ada sesuatu yang tidak biasa yang menghalangi saluran udara paru-paru Anda atau membuatnya terlalu sempit.
Produksi Dahak Berlebih
Lendir atau disebut dahak diproduksi oleh saluran udara sebagai pertahanan terhadap infeksi atau iritasi. Jika produksi lendir bertahan selama sebulan atau lebih, ini bisa mengindikasikan penyakit paru-paru.
Batuk Darah
Jika mengalami batuk darah, mungkin itu berasal dari paru-paru atau saluran pernapasan bagian atas. Dari mana pun asalnya, itu menandakan adanya masalah kesehatan paru-paru.
Nyeri Dada Kronis
Nyeri dada yang tidak dapat dijelaskan dan berlangsung selama satu bulan atau lebih bisa jadi tanda awal gejala kerusakan paru-paru. Biasanya, rasa nyeri akan semakin parah saat bernapas atau batuk.